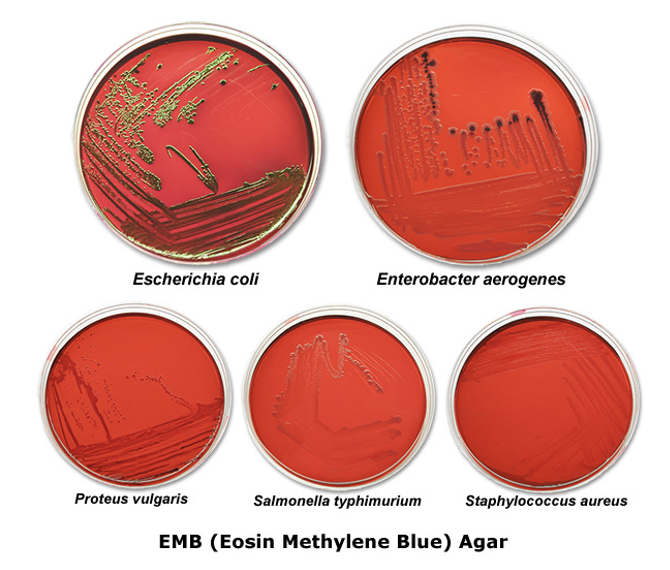
<p>EMB which is differential for lactose fermentation. Metabolising the lactose in the media will produce acid byproducts. This liquefies the dye and the bacteria can pick it up. </p>
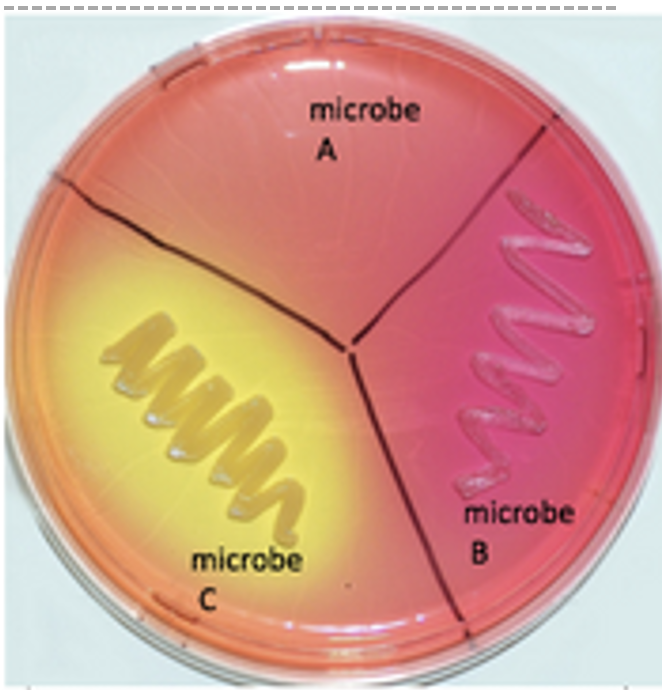
<p>selective for bacteria that can withstand salt and differential for bacteria that can ferment mannitol</p>
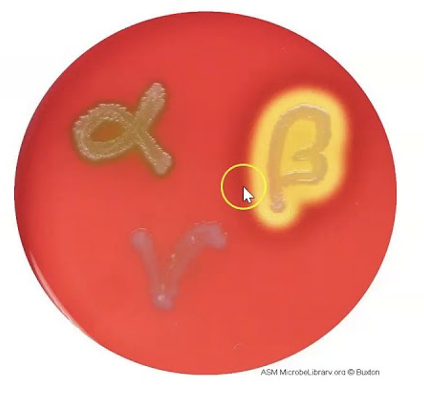
<p>hemolysin assay</p>

1/116
Looks like no tags are added yet.
Name | Mastery | Learn | Test | Matching | Spaced | Call with Kai |
|---|
No analytics yet
Send a link to your students to track their progress
What do bacteria need to grow?
media which is a source of macro and micronutrients
What is complex media?
made of peptones and beef extract but we don’t know the exact quantities of nutrients
What is chemically defined media?
when we know the exact concentration of nutrients in the media
What is agar?
a solidifying agent derived from red seaweed
When do we use an agar plate?
when we want to isolate a single colony
When should liquid broth be used?
if you want to see lots of bacterial growth quickly
Why is slant agar used?
Uses less materials and space. Allows you to keep bacteria growing if you don’t need a pure culture
What can semi-solid agar show?
When inoculated with a needle all the way to the bottom, where the bacteria choose to gather can highlight its preferences for oxygen
How can semi-solid agar help infer a bacteria’s motility?
There could be a Christmas tree-like shape forming at the point of inoculation. Or, the agar becomes cloudy, indicating that the bacteria can move through it
What is selective media?
selects for the growth of some microbes and against the growth of others
Give an example of a selective media?
EMB which is selective for gram negative bacteria. It contains aniline dyes which inhibit the growth of gram positive organisms
What does differential media do?
changes the color or appearance of certain microbes which indicates a unique quality
Give an example of a differential media?
EMB which is differential for lactose fermentation. Metabolising the lactose in the media will produce acid byproducts. This liquefies the dye and the bacteria can pick it up.
What kind of media is mannitol salt?
selective for bacteria that can withstand salt and differential for bacteria that can ferment mannitol
If bacteria doesn’t grow on mannitol salt media, what does that mean?
It can’t withstand salt but you can’t say that it’s unable to ferment mannitol
What is blood agar used for?
hemolysin assay
Is blood agar differential or selective?
differential because the results differ based on the characteristics of bacteria
Why are obligate intracellular microbes hard to grow in a lab?
they require cell culture so you need to determine the conditions that their host cells need to grow
Provide examples of obligate intracellular microbes
Rickettsia and Chlamydiae
provide examples of facultative intracellular microbes
Legionella, Listeria and Mycobacterium
How do obligate aerobes appear in semi-solid media?
all close to the top

How do obligate anaerobes appear in semi-solid media?
clumped at the bottom

How do facultative anaerobes appear in semi-solid media?
mostly at the top but some scattered throughout

What do facultative anaerobes typically?
do oxygenic respiration if oxygen is available
How do aerotolerant anaerobes appear in media?
spread throughout the media because they have enough defence mechanisms against oxygen and ROS

How do microaerophiles appear in media?
in the middle because they like having a little bit of oxygen

How can the electron transport chain unintentionally create ROS?
At the end, when electrons are added to oxygen, water isn’t always made
Give examples of ROS
peroxide ion, hydroxyl radical, superoxide free radicals
What makes ROS so reactive?
they have unpaired electrons
How can ROS affect proteins?
change the 3D structure which can alter their function
What can ROS do to lipids?
lipid peroxidation which weakens the cell membrane
How can ROS affect DNA?
damage DNA so new nucleotides are made
What do antioxidants do?
convert ROS back into stable molecules
Give examples of antioxidants
Vitamin C, polyphenols, Vitamin E and A
What’s one way to culture anaerobic bacteria?
using reducing media which contains chemicals that deplete any oxygen
What chemicals might be used in reducing media?
oxyrase and thioglycolate which consume oxygen
What’s another way to culture anaerobic bacteria?
placing them in an anaerobic jar with a gas pack containing sodium bicarbonate
How does the anaerobic jar work?
the gas pack releases carbon dioxide and hydrogen. The hydrogen reacts with any oxygen in the jar to make water
What’s a third way to work with anaerobic bacteria?
An anaerobic chamber which is free of oxygen. Instead, an inert gas is pumped in
What are capnophiles?
microbes that require high CO2 conditions
Where are capnophiles found?
intestines, respiratory tract and body tissues as they are low in oxygen and high in CO2 due to gas exchange
How do we study capnophiles?
CO2 packet or by placing plates in a jar with a candle
How does placing a lit candle into a jar deplete oxygen?
The fire needs oxygen to keep burning. So, it will use it all up
Provide examples of capnophiles?
Streptococcus pneumoniae which causes middle ear infections, meningitis and pneumonia
Neisseria gonorrhoeae
Haemophilus influenza
What is doxorubicin?
an antibacterial agent that inhibits the FtsZ ring that bacteria use in binary fission
What does binary fission create?
equally sized products of cell division
What types of bacterial cell division creates unequal products?
simple budding, budding from hyphae, cell division of stalked organisms

How is bacterial growth measured?
As the log(10) number of cells over time
What is generation time?
time that it takes one cell to divide into 2
What is the lag phase of growth in liquid culture?
bacteria adjusting to it’s new environment and there’s no considerable growth

What is the log phase of growth in liquid culture?
when there’s a continuous doubling

What is the stationary phase of growth in liquid culture?
the number of bacteria growing = the number of bacteria dying

What is the death phase of growth in liquid culture?
nutrient availability decreases and quorum sensing could play a role

Compare the lengths of the 4 stags of growth in liquid culture from longest to shortest
4 > 2 > 3 > 1
What is a continuous culture?
used to keep bacteria in the log phase by adding in fresh media and pumping out old media at a steady rate
What’s one way to determine bacterial number in a liquid culture?
Doing plate counts following dilutions of tenfold several times

What number of colony forming units is desirable for counting
20-250
How do you calculate CFU/ml?
(bacterial colonies counted x dilution factor) / volume plated
Why does the spread plate method promote the growth of aerobic microbes?
you spread the dilution over the top of the media which is exposed to oxygen
What is the pour plate method?
inoculating an empty plate, then adding melted agar and mixing it in. Bacteria will grow in and on top of the solidified media
Why is the pour plate method helpful?
it allows for the growth of anaerobic and aerobic bacteria
When is membrane filtration used to count bacteria?
if you have a liquid that shouldn’t have a lot of bacteria
How does membrane filtration work?
Pour liquid through a membrane filter. Bacteria are too large to go through the pores so they get stuck. Transfer the filter to media then count.
What’s direct microscopic count?
Use a hemocytometer which is a microscope slide with a grid. Count the number of bacteria cells you can see in the grid
When is it best to use direct microscope count?
For bacteria that are big enough to see
What does turbidity refer to?
the cloudiness of a solution
How does a spectrophotometer work?
it measures optical density by sending a specific wavelength of light, then it measures how much light is absorbed
The higher the absorbance…
the more turbid the solution which means there’s more bacteria
What’s one way to use turbidity?
to compare relative bacterial growth between samples
What’s an additional way that turbidity can be used?
To create a standard curve by comparing the absorbance values to the bacterial number from CFU count
What does sterile mean?
the absence of microbes, cells, spores and acellular entities
What is sepsis?
life threatening disease where bacteria are released into the bloodstream
What is aseptic?
absence of contamination
What is antiseptic?
antimicrobial applied to living tissue
What is disinfectant?
antimicrobials applied to non-living objects
What does the effectiveness of treatment depend on?
Number of microbes, environment (e.g temperature and pH), time of exposure, concentration and microbial characteristics (endospores, glycocalyx, biofilm)
What are examples of physical agents that can control microbial growth?
heat sterilisation, desiccation, radiation, sonic waves and pressure
What’s one method of heat sterilisation?
An autoclave which uses pressured steam to denature proteins. This is used on equipment
What’s another method of heat sterilisation?
flaming and incineration to break down biological materials
When is pasteurisation used?
used on food for a short amount of time to kill most bacteria without changing the quality of the food
Why does freezing kill bacteria?
causes ice crystals to form in the bacterial cells
What does psychrophilic mean?
likes extreme cold
What does hyperthermophilic mean?
likes extreme hot temperatures
What does mesophilic mean?
likes the temperature of the human body
What is desiccation?
Loss of water. The dehydration blocks metabolism so the microbes can’t grow
How does radiation kill bacteria?
Microwaves causes vibration of water molecules which punctures cells. Gamma rays, UV and X rays cause DNA damage and the formation of free radicals
How could purple light be used?
Bacteria are sensitive to it but we aren’t so it could be used in hospitals or the operating room to keep it sterile
How do sonic waves kill bacteria?
the wave vibrations increases the membrane permeability which alters the composition of the membrane, polarises it and makes it less fluid
How does pressure kill bacteria?
it changes the shape and structure of the bacterial cells so they die
How does the disc diffusion assay work?
Do spread plate technique, then add paper discs each soaked in a different chemical, then incubate
The greater the zone of inhibition around the paper disc…
the more sensitive the bacteria is to that chemical
What is the use-dilution test?
soak steel rings into bacterial culture, then into disinfectant. Next, place them into growth broth to determine if any have surviving bacteria
What do phenols, bisphenol and phenolics do?
disrupt plasma membranes and denatures proteins
What is lysol an example of?
a phenol that acts as a disinfectant
How do oxygen-releasing materials kill bacteria?
by oxidising microbial enzymes
How does iodine kill bacteria?
alters protein synthesis and lipid membranes
How does chlorine kill bacteria?
it’s an oxidising agent that can be added to water as gas, hypochlorite or an organic chlorine derivative
What is bleach?
hypochlorous acid
How do alcohols kill bacteria?
they denature proteins and dissolve lipids
Give examples of heavy metals
silver, mercury, copper and bismuth